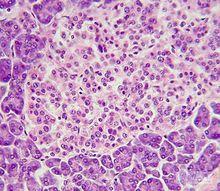
人工合成完整人類細胞

十年之內合成人類完整細胞據
人工合成完整人類細胞
人工合成完整人類細胞英國每日郵報報導,目前,科學家宣布了一項宏偉計畫,將在10年之內人工合成完整的人類細胞。
這項計畫涉及到人工合成人類全部DNA代碼的60億鹼基,研究人員指出,如果這一項目得以順利進行,將有助於研究癌症等疾病,甚至可以培育可替換的器官組織。同時,該研究也將提高公眾對“設計嬰兒”的關注度。
 人工合成完整人類細胞
人工合成完整人類細胞科學家希望人工合成完整DNA植入活體細胞,很有可能細胞會分裂。這將是科學家首次設計完整的人類細胞。這一項目被命名為“人類基因組計畫改寫”,有助於研究人員製造用於研究的合成人類基因和染色體。
這項研究意義深遠,可以培育器官組織移植在患者體內,對致命病毒實現免疫化控制,例如:伊波拉病毒和寨卡病毒等,甚至可以在實驗室內培育抗癌細胞。
這項最新研究報告發表在《科學》雜誌上,研究負責人、美國紐約大學傑夫-博克(Jef Boeke)教授稱,“人類基因組計畫改寫”是一個自然發展進程,將使人類基因研究從“讀取模式”轉變成為“改寫模式”。
